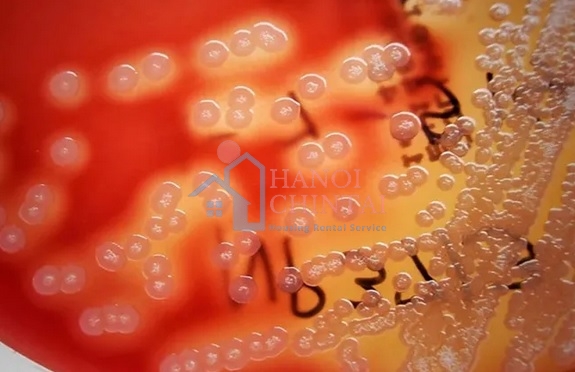

Kết hợp sợi đay tự nhiên với vi khuẩn Bacillus pumilus có thể cải thiện độ bền của bê tông
Nghiên cứu gần đây cho thấy việc kết hợp sợi đay tự nhiên với vi khuẩn Bacillus pumilus mang lại hiệu quả rõ rệt trong việc nâng cao cường độ uốn, độ dai và tuổi thọ của bê tông. Đây là một hướng tiếp cận mới, kết hợp giữa gia cường cơ học bằng sợi sinh học và cơ chế tự khoáng hóa vi sinh, phù hợp với xu thế vật liệu xây dựng xanh và phát thải thấp.
Trong bối cảnh ngành xây dựng ngày càng quan tâm đến vật liệu thân thiện môi trường và tuổi thọ công trình, các giải pháp bê tông cốt sợi tự nhiên và công nghệ sinh học đang thu hút nhiều nghiên cứu. Việc tận dụng đặc tính của vi sinh vật để cải thiện vi cấu trúc bê tông được xem là hướng đi tiềm năng nhằm nâng cao tính năng cơ học và độ bền lâu dài của vật liệu.
Ảnh hưởng của quá trình kết tủa do vi khuẩn Bacillus pumilus đến cường độ uốn của bê tông cốt sợi đay.
Một nghiên cứu vừa được công bố trên tạp chí Scientific Reports đã tập trung đánh giá hiệu quả của vi khuẩn Bacillus pumilus, một chủng vi khuẩn sinh bào tử có khả năng chịu môi trường kiềm cao và kích hoạt quá trình kết tủa canxi cacbonat trong bê tông, khi được kết hợp với bê tông cốt sợi đay. Nghiên cứu này nhằm làm rõ tác động của công nghệ kết tủa canxi cacbonat do vi khuẩn đối với cường độ uốn và khả năng chống suy thoái của bê tông cốt sợi tự nhiên.
Bê tông thông thường có cường độ kéo và cường độ uốn thấp, dễ xuất hiện vết nứt và phá hoại giòn khi chịu tải. Việc bổ sung sợi vào nền bê tông giúp hạn chế sự phát triển của vết nứt, tăng khả năng phân tán ứng suất và nâng cao độ dẻo của vật liệu. Trong số các loại sợi tự nhiên, sợi đay được đánh giá cao nhờ hàm lượng cellulose lớn, khối lượng riêng thấp và cường độ kéo tương đối tốt. Cấu trúc vi sợi và thành phần hóa học của sợi đay cũng tạo điều kiện cho sự liên kết cơ học với các sản phẩm khoáng trong bê tông.
Tuy nhiên, sợi đay và các loại sợi tự nhiên khác dễ bị suy giảm chất lượng trong môi trường bê tông có tính kiềm cao, đồng thời có xu hướng hút ẩm và hình thành vùng liên kết yếu với nền xi măng. Những yếu tố này làm giảm độ bền lâu dài của bê tông cốt sợi tự nhiên. Các biện pháp xử lý hóa học đã được thử nghiệm nhưng thường tiêu tốn nhiều năng lượng, chi phí cao và chưa mang lại hiệu quả bền vững.
Nghiên cứu đã đề xuất sử dụng công nghệ kết tủa canxi cacbonat do vi khuẩn Bacillus pumilus như một giải pháp sinh học thân thiện môi trường. Vi khuẩn này có khả năng thủy phân ure, tạo ra ion cacbonat phản ứng với ion canxi để hình thành canxi cacbonat. Các tinh thể canxi cacbonat lắng đọng trong lỗ rỗng, vi nứt và đặc biệt tại vùng tiếp giáp giữa sợi đay và nền bê tông, từ đó cải thiện liên kết và làm đặc chắc cấu trúc vật liệu.
Trong thí nghiệm, các nhà nghiên cứu sử dụng xi măng portland thông thường mác 42,5 R, cốt liệu mịn và cốt liệu thô tự nhiên, sợi đay và dung dịch vi khuẩn Bacillus pumilus với 3 mật độ tế bào khác nhau. Sợi đay được xử lý bằng dung dịch natri hydroxit nồng độ 5% nhằm làm sạch bề mặt và tăng khả năng bám dính, sau đó được ngâm trong dung dịch vi khuẩn để tạo điều kiện cho vi khuẩn bám lên sợi.
Hỗn hợp bê tông được thiết kế với tỷ lệ cốt liệu thô cốt liệu mịn xi măng là 4:2:1, tỷ lệ nước trên xi măng là 0,55. Một phần nước trộn được thay thế bằng dung dịch vi khuẩn. Các mẫu dầm bê tông kích thước 150 x 150 x 500 mm được đúc và bảo dưỡng trong các mốc thời gian 7, 14, 21 và 28 ngày trước khi tiến hành thí nghiệm uốn 3 điểm.
Kết quả cho thấy mật độ vi khuẩn Bacillus pumilus có ảnh hưởng đáng kể đến tính chất của bê tông. Ở mật độ thấp, hiệu quả cải thiện cường độ xuất hiện sớm nhưng không rõ rệt. Mật độ trung bình cho thấy sự gia tăng cường độ ở giai đoạn muộn hơn. Trong khi đó, mật độ vi khuẩn cao nhất mang lại cường độ uốn tại 28 ngày lớn nhất, dù đồng thời làm giảm độ linh động của hỗn hợp bê tông tươi.
Các thử nghiệm độ bền trong môi trường axit cho thấy bê tông có bổ sung vi khuẩn Bacillus pumilus có mức suy giảm khối lượng và kích thước thấp hơn so với mẫu đối chứng. Phân tích hiển vi điện tử quét xác nhận sự hình thành dày đặc của canxi cacbonat trong cấu trúc bê tông, sự cải thiện rõ rệt của liên kết giữa sợi đay và nền bê tông, đồng thời cho thấy mạng lưới vi nứt bị thu hẹp và gián đoạn.
Kết quả nghiên cứu khẳng định rằng việc kết hợp sợi đay với công nghệ kết tủa canxi cacbonat do vi khuẩn Bacillus pumilus có thể nâng cao đáng kể cường độ uốn và độ bền của bê tông. Đây là một hướng phát triển vật liệu bê tông sinh học giàu tiềm năng, góp phần tận dụng nguồn sợi tự nhiên, giảm phụ thuộc vào vật liệu tổng hợp và hướng tới các giải pháp xây dựng bền vững trong tương lai.
Theo Azobuild/ximang.vn


















